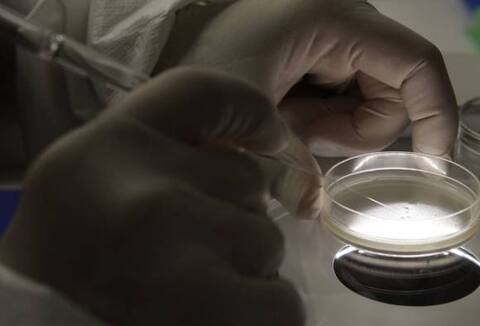

২৫ বছর ধরে সংরক্ষিত ভ্রূণ থেকে জন্মাল কন্যাসন্তান
Web Desk, ABP Ananda | 20 Dec 2017 06:30 PM (IST)
ফাইল ছবি
ওয়াশিংটন: ২৫ বছর ধরে সংরক্ষণ করে রাখা ভ্রূণ থেকে সন্তানের জন্ম দিলেন মার্কিন যুক্তরাষ্ট্রের এক মহিলা। এটাই সবচেয়ে বেশি সময় ধরে সংরক্ষণ করে রাখা ভ্রূণ থেকে সন্তান জন্ম দেওয়ার ঘটনা। এর আগে ২০ বছর ধরে সংরক্ষিত একটি ভ্রূণ থেকে এক শিশুর জন্ম হয়েছিল। এবার সেই রেকর্ড ভেঙে গেল। ১৯৯২ সালের ১৪ অক্টোবর ওই ভ্রূণটি সংরক্ষণ করা হয়। সেই ভ্রূণ থেকেই সন্তানের জন্ম দিলেন টিনা গিবসন নামে এক মহিলা। তাঁর স্বামী বেঞ্জামিন গিবসন সিস্টিক ফাইব্রোসিস রোগে ভুগছেন। ফলে টিনার পক্ষে সন্তানের জন্ম দেওয়া সম্ভব হয়নি। তাঁরা এর আগে কয়েকটি সন্তান দত্তক নেন। তবে টিনা সন্তানের জন্ম দিতে চাইছিলেন। সেই কারণে এ বছরের ১৩ মার্চ তিনি ভ্রূণ দান কেন্দ্র থেকে ভ্রূণটি নেন। ২৫ নভেম্বর কন্যাসন্তানের জন্ম হয়। তার নাম রাখা হয়েছে এমা রেন গিবসন। সে সুস্থই আছে। টিনা বলেছেন, ‘বিশ্বরেকর্ড করলাম কি না জানি না, আমি একটা সন্তান পাওয়ার জন্য মরিয়া হয়ে উঠেছিলাম। আমার বয়স ২৫, ভ্রূণটারও বয়স একই। আমি আর এই ভ্রূণটা ভাল বন্ধু হতে পারতাম।’